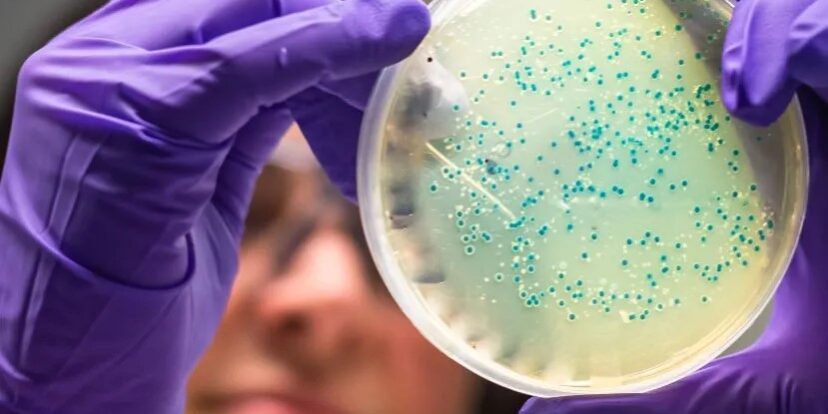
20240909_magazin_mikrobium_01_nyito

Mindenkinek van, de mindenkinek más: mi az a mikrobiom, és hogyan hat az életünkre?
Sosem vagyunk teljesen egyedül. A testüregeink, a bélrendszerünk és a bőrünk milliárdnyi mikrobának adnak otthont, a fenntartásból pedig ők is bőven kiveszik a részüket. Becsüljük meg őket!
Kívül-belül
Baktériumok, gombák és vírusok sokasága van jelen a testünkön és a testünkben. Ettől nem kell megijedni, teljesen természetes. Sokuk rendkívül fontos szerepet tölt be az életünkben, befolyásolják az emésztésünket, az immunrendszerünk működését, az egészségünket, sőt, a hangulatunkat, a mentális egészségünket is [1]. Bár az „antibakteriális” kifejezés mágikus szóvá vált a legkülönfélébb termékek esetében – zoknitól kezdve tisztítószerekig sokfelé találkozhatunk vele –, és hétköznapi dolog antibiotikumot szedni, amikor megbetegszünk, valójában rengeteget köszönhetünk a mikrobáknak [2, 3]. Hihetetlenül rossz ötlet lenne arra törekedni, hogy eltöröljük őket a Föld színéről [3], vagy akár csak a saját szűk környezetünkből.

Elsőként a bélrendszerünkre gondolunk, ha szóba kerül a mikrobiom, de az egész környezetünket körbeveszi. Fotó: Canva
Szó sincs arról, hogy ne léteznének az egészségünkre nézve veszélyes mikrobák, vagy hogy az antibiotikumok minden esetben elítélendők. Az igazsághoz hozzátartozik az is, hogy komoly stresszhatások esetén ellenünk fordulhatnak akár olyan mikrobák is, amelyek normális körülmények esetén kölcsönösen előnyös kapcsolatban állnak velünk. Mégis, ha a teljes képet nézzük, ezek a parányi lények óriási szerepet játszanak az életünkben – pozitív értelemben. Világuk, mely természetesen messze túlterjed a szervezetünkön, igazán lenyűgöző.
Különbözik, változik
Az emberi mikrobiom mindenkinél más, de az eltérés mértékében érdekes módon vannak különbségek. Az iparosodott társadalmakban nagyobbak az egyének közti különbségek. Mikrobiomunk összetétele a testünk egyes részein eltérő mértékben ugyan, de változik. Változások egészen különböző időléptékekben, pár órás és több éves távlatban is bekövetkeznek [1]. Van valami, ami viszont a legtöbb embernél hasonló (bár nem minden időpontban): a testünkben lévő sejteknek mindössze megközelítőleg a fele hagyományos értelemben a sajátunk, a másik fele a velünk élő baktériumoké [4].
Részben örököljük, de a környezet szerepe hatalmas
Döntően a környezet határozza meg az emberi bél-mikrobiomot, nem az egyén genetikai háttere. A különféle típusú környezetek a mikrobiommal összefüggésben egészen eltérő egészségügyi hatásokkal járnak [2]. Mikrobiomunkat környezetünk biológiai változatossága, a háznál tartott állatok és társadalmi interakcióink mind alakítják [5].

Már a születésünk módja is befolyásolja a teljes mikrobiomunkat és annak fejlődését. Fotó: Canva
Életre szóló kezdetek
Az, hogy a korai életszakaszokban milyen hatások érnek minket, egész életünkre kiterjedő hatásokkal jár a mikrobiommal összefüggésben [1, 5]. A születés módja – természetes hüvelyi úton vagy császármetszéssel – és helyszíne (kórházi vagy otthoni környezet), a korai életszakaszokban kapott antibiotikumok és a társas érintkezések mind hosszú távon befolyásolják az életünket ezen a módon is [5]. A szülésnél a természetes út és az otthon szülés kedvezőbb a mikrobiom szempontjából.
Rosszul bánunk velük
A császármetszések emelkedő száma, a nyugatias életmód terjedése nagy mértékben kedvezőtlen irányba formálja a mikrobiomunkat. Többek között ez állhat a nem fertőző, mégis járványszerűen terjedő civilizációs betegségek hátterében [2, 5, 6, 7]. Az iparosodáshoz és a városiasodáshoz kapcsolódó változások nagyon összetettek. Ezek a folyamatok az étrendtől kezdve a környezettől való technológiai elszigetelődésen keresztül rengeteg változást hoztak, a mikrobiomunk és az emberi szervezet együttes fejlődése azonban nem ilyen körülmények között zajlott [6]. Ez rányomhatja a bélyegét a mikrobiomunk – és így saját magunk – egészségére. Ide kapcsolódik a túlzásba vitt higiéniai, tisztálkodási szokások és az alkalmazott tisztálkodószerek hatása is. Az antibiotikumok nyakló nélküli használata a gyógyászatban (és a mezőgazdaságban) pedig – amellett, hogy megtépázza a számunkra fontos baktériumközösségeket – hozzájárul az antibiotikum-rezisztencia terjedéséhez, aláásva ezzel a lehetőségeinket a valóban veszélyes bakteriális betegségek elleni védekezésre.

Figyeljünk a túl sok antibiotikummal, de a felesleges fertőtlenítés és a feldolgozott ételek se tesznek jót a mikrobiomunknak. Fotó: Canva
Mit tehetünk a mikrobiomunkért, az egészségünkért?
Az imént felvetett problémákra mind léteznek megoldások [6, 7, 8, 9, 10]. Király Ágnes pár éve megjelent könyvének kapcsolódó fejezete alapos áttekintést ad a témakörről. A szakirodalom alapján többek között a következő tanácsokat érdemes megfogadnunk:
- Étkezzünk változatosan, kerüljük az erősen feldolgozott élelmiszereket [5, 8, 9]!
- Fogyasszunk élelmi rostokat, de ne csak gabonákból [7, 8]! Együnk, igyunk fermentált ételeket és italokat [8]!
- Töltsünk minél több időt a szabadban, változatos természeti környezetben [5, 10]!
- Érintkezzünk többet az élettel teli talajjal és más élőlényekkel [5, 8]!
- Törekedjünk a vegyszerhasználat minimalizálására a háztartásban is [8]!
- Mozogjunk rendszeresen [8]!
Mindezekkel ráadásul a mikrobaközösségeinkre gyakorolt hatáson kívül is jobbá, egészségesebbé tehetjük az életünket, ökológiai szempontból is kedvező módon.
Felhasznált irodalom:
[1] Gilbert, J. A., Blaser, M. J., Caporaso, J. G., Jansson, J. K., Lynch, S. V., & Knight, R. (2018). Current understanding of the human microbiome. Nature medicine, 24(4), 392–400.
[2] Callewaert, C., Ravard Helffer, K., & Lebaron, P. (2020). Skin Microbiome and its Interplay with the Environment. American Journal of Clinical Dermatology, 21(1), 4–11. (szemle magyarul itt)
[3] Gilbert, J. A., & Neufeld, J. D. (2014). Life in a world without microbes. PLoS biology, 12(12), e1002020.
[4] Sender, R., Fuchs, S., & Milo, R. (2016). Are we really vastly outnumbered? Revisiting the ratio of bacterial to host cells in humans. Cell, 164(3), 337–340.
[5] Renz, H., & Skevaki, C. (2021). Early life microbial exposures and allergy risks: opportunities for prevention. Nature Reviews Immunology, 21(3), 177–191. (szemle magyarul itt)
[6] Dominguez-Bello, M. G., Godoy-Vitorino, F., Knight, R., & Blaser, M. J. (2019). Role of the microbiome in human development. Gut, 68(6), 1108–1114.
[7] Deehan, E. C., & Walter, J. (2016). The fiber gap and the disappearing gut microbiome: implications for human nutrition. Trends in Endocrinology & Metabolism, 27(5), 239–242.
[8] Király, Á. (2021). Mikrobiombarát életmód. In: Egyszerűen fermentálj. Budapest, HVG Könyvek, 369–389.
[9] Heiman, M. L., & Greenway, F. L. (2016). A healthy gastrointestinal microbiome is dependent on dietary diversity. Molecular metabolism, 5(5), 317–320.
[10] Aerts, R., Honnay, O., & Van Nieuwenhuyse, A. (2018). Biodiversity and human health: mechanisms and evidence of the positive health effects of diversity in nature and green spaces. British medical bulletin, 127(1), 5–22. (szemle magyarul itt)
Kiemelt kép: Canva
Szöveg: Pribéli Levente
Forrás: Greendex.hu